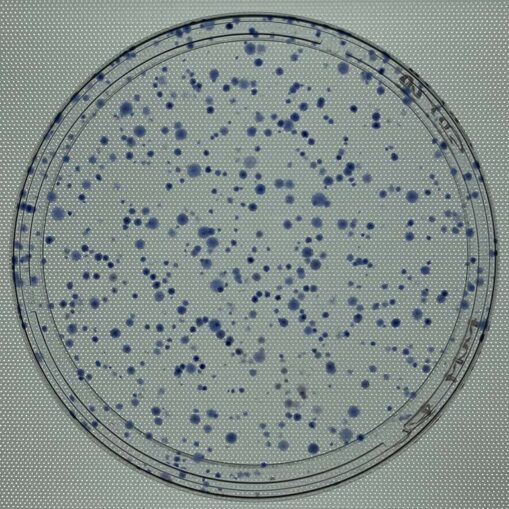
Photo of transposition assay

About half of the human genome isn’t quite human. It’s made up of transposable elements (TEs)—descendants of ancient viruses. As a Ph.D. student at the Max-Delbrück Center for Molecular Medicine, Andrea Schorn studied an ancient TE that was resurrected from fish and is active in pretty much all vertebrates—except fish. Today, Schorn is an assistant professor at Cold Spring Harbor Laboratory (CSHL). We visited her lab for an inside look at the ancient, non-human origins of DNA. It turns out Schorn’s work could lead to new strategies for improving pregnancy outcomes and fending off viruses like HIV.
[Questions and answers have been edited for clarity.]
What is the focus of your lab’s research?
We work on transposable elements, or transposons. Specifically, we work with old retroviruses—viruses that infected genomes millions of years ago or sometimes only recently. We’re interested in how the host can recognize and silence them when they become active. Usually, they’re only active in early development—but also sometimes in disease. When transposons are active, they can move or jump around cells and turn genes on and off.
How did you get into studying transposons and retroviruses?
I was always interested in RNA and host-pathogen interactions. I became very interested in transposons because it appeared they have a lot to do with how the cell combats invaders. Cells have a defense mechanism built on RNA and a memory of which viruses and transposons they’ve been exposed to.
What questions do you hope to answer with your research?
We want to know how RNA can tell whether a retrovirus or transposon is good or bad. Half our DNA is made up of these TEs and old retroviruses. They can be bad if they’re active and move around, but they can also be very good.
Hosts have adopted genes from retroviruses over the years, and they’ve become essential. It’s a bit like Lego. At first, the pieces are able to move around, but at some point, you have essential infrastructure you can’t take away. So, we are now in this place where we need them but also need to make sure we can sense, control, and manage them.
Which RNAs are you focused on?
The retroviruses we study use transfer RNAs (tRNAs)—an essential RNA component in the cell—to replicate. It turns out the cell cleaves tRNAs into many pieces and uses them to find and suppress retroviruses. It’s a very interesting example of small RNAs because we think they’re probably quite ancient, and they’re in all cells.
How ancient are we talking here?
We can only speculate when it comes to evolution, but tRNAs certainly were one of the first molecules to enable life. Then, retroelements brought the machinery to make DNA out of RNA.
There’s this “RNA world” hypothesis where there was no DNA as storage for information, but it was all RNA doing everything. RNA can be an enzyme. It can provide code to find transposons. It can be the instructions for making a protein. So, tRNA could be very ancient. It kind of started an evolutionary arms race: the need to suppress transposon mobility, but also using them as building blocks.
Step into CSHL Assistant Professor Andrea Schorn’s lab for a behind-the-scenes look at the parts of our genome that aren’t quite human.
Why did these ancient retroelements end up sticking around?
We think there are so many in our genome because they’ve become so useful. Originally it was probably like any other infection—kind of obnoxious or a problem. But then, the ones we see today and study as transposons managed to invade the germline of organisms—the cells of the next generation. Whenever that happened, they were able to have a foothold in that organism and be inherited over and over.
They’ve hitched a ride throughout human evolution?
Exactly. There has been a transition in the field. In the past, transposons were often called parasites to emphasize their dangerous behavior. But today, there’s much more appreciation for their benefits and how they’ve supplied building blocks to the cell.
How do they affect us during development and disease?
Some of the negative effects are their mobility. They move somewhere and destroy a gene or region. The other effect we’re studying more today is that they drive the expression of neighboring genes. They attract these epigenetic marks to the DNA to affect whether the entire region is active or inactive.
During development, they drive active gene expression, which is desired in this case. But during disease, like in cancer, this is unintended. They drive neighboring genes that become oncogenes and were not supposed to be expressed in the cell. They mess up gene expression.
Can you tell us more about their benefits?
TEs that get reactivated during development help define which regions are active. They are like the on switch in certain times of development, and then they need to be turned off for proper development to proceed.
Today, we know some examples of how they’ve been domesticated and are essential. One famous example is a protein called Syncytin, an old virus envelope protein that can fuse to other cells. In mammals, it helps the placenta, which is a part of the embryo, to invade the mother’s tissue. This happened multiple independent times in evolution—in rabbits, mice, and humans. But if you take the protein away, the pregnancy will fail.

What about the unintended effects you mentioned?
It’s basically an aberrant gene expression. That could be cancer or neurological defects. We will need more research to see if this is a consequence or causal—that’s not clear. There are examples where transposons jumped into key genes in colorectal tumors, contributing to uncontrolled cancer growth.
Are there examples where it doesn’t result in cancer or disease? Like how Barbara McClintock’s corn changed color?
There are many examples where we can “see” transposon activity, often in adult cells. The corn you mentioned is a classic example. The change between pinot grigio and pinot noir is basically a transposon inserted into a color gene. There’s a famous fur color pattern variation in mice, associated with obesity.
And because transposons hitchhike from parent to child, that trait gets passed down?
If the transposon jumped the geneline, like in pinot. However, in Agouti mice, the transposon has been there all along and sporadically escapes the epigenetic on-off switch, which leads to the trait popping up in some offspring.
Can you give us a preview of what you’re working on now?
We’re studying transposons in stem cells, and how tRNA fragments recognize and regulate retroviruses in mice and humans. They are a relatively novel small RNA class. They clearly overlap with other RNA silencing pathways. How are they similar and how are they different? How many genes are regulated by this? How pervasive is this type of control? Given that tRNAs are precious, essential molecules, what’s behind the decision to cleave them? How can cells tell a bad retrovirus from a good, domesticated one?
RNA silencing is like a primitive immune system. We can think of this very much in evolutionary terms. How did it evolve, and how does it sort out which RNAs are OK and which are not? I think retroviruses are key to this question. How do you tell whether a retrovirus is still dangerous and actively jumping around within the cell or settled down, essential, and on the good side?
Are the retroviruses of old related to viruses that infect us today?
Yes, the type of transposons we work on are all retroviruses, and they’re directly related to HIV. Generally speaking, viruses come in many different flavors, but they’re infectious. They can spread between cells and individuals. Transposons come in different classes, but they stay within one cell. There’s an overlap because some of the retroviruses that infected us became transposons.
What kind of human-health impacts do you hope this work will have?
Once we understand better how tRNA fragments recognize these types of transposons, we can learn how to prevent or manage retrovirus infection. These small RNAs are also strongly expressed and abundant in early embryo stem cells. So, understanding how tRNA fragments know friend from foe could help improve pregnancy outcomes, because this is a time transposons go rogue.
The same process that happens in early embryo stem cells often happens in cancer cells. Many cancer cell types and tumors have very high transposon expression. So, if we could use tRNA fragments to control and inhibit them, we could get a handle on cancer. We could improve patient care and outcomes.
Ancient viral invaders don’t just sound cool. They’re part of us. Over millions of years, retroviruses and other transposons have become essential to human development. Thanks to the work of Andrea Schorn, they may also provide essential clues for improving pregnancy outcomes and treating diseases like cancer and HIV. Where will these clues emerge, and where will they take us next? We’ll be watching closely.
Written by: Nick Wurm, Communications Specialist | wurm@cshl.edu | 516-367-5940
About

Andrea Schorn
Assistant Professor
Cancer Center Member
Ph.D., Max-Delbrück Center for Molecular Medicine, Freie Universität Berlin, 2009
